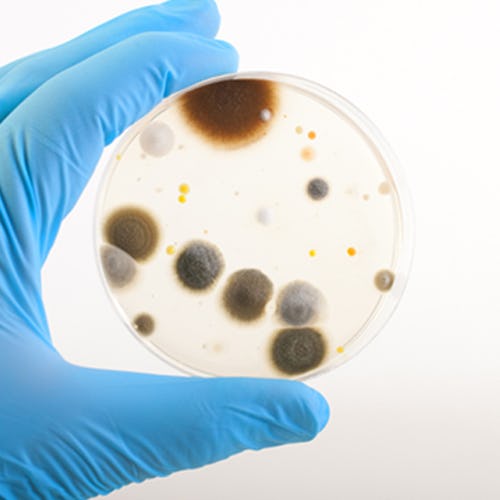

Yves De Groote
Redacteur VMT Food België

Redacteur VMT Food België


Het nieuwe Europese S3FOOD-project stimuleert agrovoedingsbedrijven om slimme sensoren in het productieproces in te schakelen. Eind dit jaar/begin volgend jaar zal de eerste call gelanceerd worden. Geadviseerd wordt alvast interesse te tonen in deelname aan het Europese project voor de agrovoedingsindustrie.

Plastic is alom aanwezig in onze maatschappij, maar binnenkort minder en minder in de winkelrekken. De handelsfederatie Comeos neemt een aantal concrete engagementen op waardoor het gebruik van plastic drastisch wordt teruggedrongen.
Vandaag worden veel procedures inzake hygiëne in de voedselverwerkende industrie nog op manuele basis uitgevoerd. Dit houdt volgens Medtradex 7 risico's in. Automatisch desinfecteren is de oplossing.
GesponsordHygiëne bij de dagelijkse productie is voor voedselproducenten- en -verwerkers meer dan ooit van het grootste belang. De huidige eisen zijn niet alleen strenger, maar komen ook uit meerdere richtingen. De door JBT ontworpen Frigoscandia vriezers voldoen aan de strengste hygiëne-eisen. Daarbij zijn ze flexibel en eenvoudig te hanteren.

Zaterdag 15 juni lanceerde Fevia haar website www.verpakkingen2025.be. Deze omvat de 6 verpakkingsengagementen van de sector richting 2025. Concrete voorbeelden van AB InBev, Alken Maes, Coca-Cola, Danone, Mars, Nestlé, Pepsico, Spadel en Unilever, tonen hoe België Europees koploper wil blijven.

Voor het eerst is de factor 'waterbeschikbaarheid' naast fotosynthese geplaatst in een digitaal 3D-plantenmodel voor soja. Dat maakt dat de groei van het gewas beter dan voorheen kan worden verklaard. In het plantenonderzoek zorgen 3D-modellen ervoor dat men het gedrag van een individuele plant als reactie op variërende omstandigheden beter begrijpt, ook los van veldexperimenten.

Delhaize test de uitbreiding van haar e-commerce netwerk uit. Vijf zelfstandige winkels nemen deel aan een proefproject waarbij klanten ook op dezelfde dag hun boodschappen online kunnen reserveren en afhalen in de winkel.

Voedings- en verpakkingsbedrijven kunnen nog tot 30 juni deelnemen aan de Greener Packaging Awards. De prijsuitreikingen in verschillende categorieën zijn op 23 oktober 2019 tijdens de verpakkingsbeurs Empack in Mechelen. De uitreiking wordt bovendien gekoppeld aan een netwerkevent en seminarie met "duurzaamheid" als rode draad.

Nieuwe FAVV-cijfers laten zien dat het aantal terugroepingen van voedingsproducten stijgt: van 53 in 2017 naar 171 in 2018. Voor Fevia toont die stijging vooral aan dat het voedselveiligheidsagentschap meer controleert en dat voedingsbedrijven hun autocontrolesysteem strikter toepassen.

Royal Agrifirm Group tekende tijdens een vergadering van de European Feed Manufacturers Federation (FEFAC) de 'Responsible Soy Declaration'. De agrarische onderneming wil hiermee een essentiële bijdrage leveren en haar verantwoordelijkheid nemen in de verduurzaming van de voedselketen.